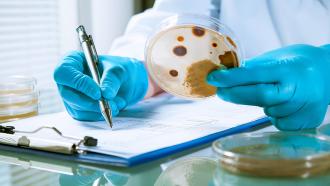
Listeria mapping tool for food recalls
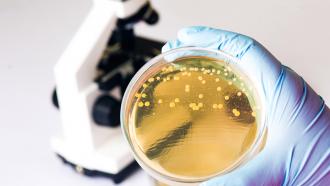
E. coli-caused hemolytic uremic syndrome (HUS)

December 21, 2021
December 14, 2021
December 2, 2021
October 12, 2021
September 28, 2021
September 20, 2021
September 14, 2021
September 9, 2021
February 10, 2021
January 13, 2021
October 6, 2020
September 29, 2020
September 14, 2020
September 2, 2020